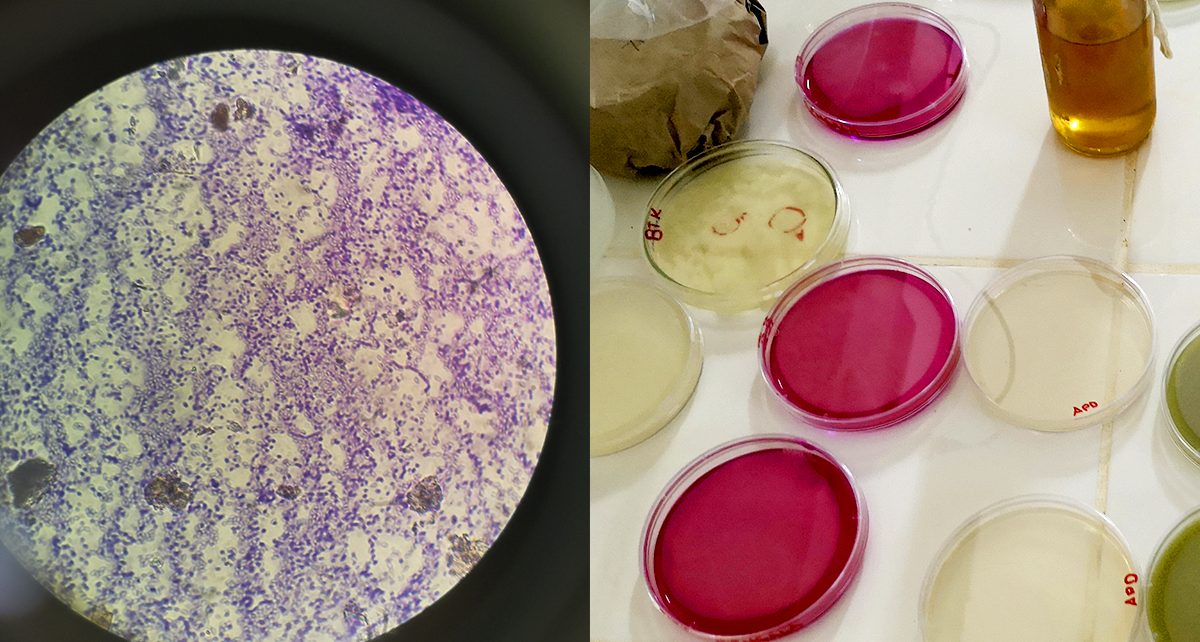

El Programa Nacional de Frutales es el encargado de generar conocimientos técnicos y científicos que permitan la innovación agraria con los actores del Sistema Nacional de Innovación Agraria (SNIA), en los principales cultivos frutícolas de nuestro país, priorizado por su importancia económicamente rentable por el incremento de las áreas de siembra a nivel nacional y Leer Más…
Autor: Christopher
Agricultores de La Libertad incrementan calidad y rendimiento de maracuyá
(La Libertad, 28 de octubre de 2020).- Agricultores del valle Santa Catalina de la región La Libertad incrementaron la producción de maracuyá de 16 a 19 toneladas por hectárea y mejoraron la calidad de pulpa, mediante la ejecución de un proyecto de innovación de tecnologías en fertilización financiado por el Ministerio de Agricultura y Riego Leer Más…
Investigadora del INIA será distinguida por Gobierno de Chile
(Lima, 26 de octubre de 2020).- El Gobierno chileno distinguirá a la investigadora cajamarquina del Instituto Nacional de Innovación Agraria (INIA), Alicia Medina Hoyos, con el “Premio 500 años”, por estudiar al maíz morado y desarrollar una nueva variedad con mayor calidad genética en beneficio de los pequeños y medianos agricultores. La distinción, una brújula Leer Más…
INIA potencia trabajos de tecnología agraria para impulsar ganadería de Amazonas
(Lima, 19 de octubre de 2020).- El Instituto Nacional de Innovación Agraria (INIA) del Ministerio de Agricultura y Riego (MINAGRI) implementó con camionetas y motocicletas a su Estación Experimental Agraria Amazonas (EEA) con la finalidad de potenciar los trabajos de investigación y de transferencia de tecnología agraria en beneficio de los pequeños y medianos productores Leer Más…
MINAGRI desarrolla nuevo camote BONDADOSA con alta calidad genética
(Lima, 13 de octubre de 2020).- El Ministerio de Agricultura y Riego (MINAGRI) ha puesto a disposición la nueva variedad de camote INIA 331 – BONDADOSA con alta calidad genética, que por sus buenas cualidades, mejorará en un 52% la rentabilidad de los pequeños y medianos productores de la costa y valles interandinos. Este nuevo Leer Más…
Agricultores de Cajamarca incrementan producción de lima y mejoran rentabilidad económica
(Cajamarca, 12 de octubre de 2020). – A más de 9 mil kilos por hectárea se incrementó la producción de lima de la Asociación de Productores Agropecuarios Señor de la Humildad en la región de Cajamarca, mediante la aplicación de técnicas de manejo productivo promovidos por el Ministerio de Agricultura y Riego (MINAGRI) mediante proyectos Leer Más…
Productores de la Convención mejoran calidad genética de cerdos con proyecto de innovación
(Cusco, 12 de octubre de 2020).- Pequeños y medianos productores de la Asociación Evangélica Cristo Camino a la Vida de la provincia cusqueña de la Convención incrementaron en un 50% la calidad genética de cerdos, mediante la ejecución de proyecto de innovación en técnicas de crianza y manejo reproductivo financiado por el Ministerio de Agricultura Leer Más…
Expertos internacionales capacitan a agricultores en uso de biotecnología para proteger calidad de cultivos
(Lima, 12 de octubre de 2020).- El Ministerio de Agricultura y Riego (MINAGRI) realiza el taller “DIVERSIDAD DE MICROORGANISMOS EN LA AGRICULTURA Y SUS USOS”, con la finalidad de fortalecer los conocimientos sobre la aplicación de estándares de controles de calidad en bioinsumos agrícolas que ayuden a potenciar la producción agropecuaria. El taller, organizado por Leer Más…
Más de 800 mil familias empoderan la crianza de cuy como actividad comercial
(Lima, 9 de octubre de 2020).- A celebrarse el Día Nacional del Cuy, la producción de cuy de más de 800 mil familias en todo el Perú ha pasado de ser una actividad familiar a una comercial, mediante el manejo y reproducción de razas de cuyes con alta calidad genética desarrollado por el Ministerio de Leer Más…
MINAGRI promueve tecnología ecológica para proteger cultivos de café del Vraem contra plagas
(Vraem, 05 de octubre de 2020).- El Ministerio de Agricultura y Riego (MINAGRI) viene promoviendo el uso de controladores biológicos en los cultivos de café de la zona del Vraem, con la finalidad de mejorar su protección ante las principales plagas, el cuidado del medio ambiente y la reducción de agroquímicos que generan daño al Leer Más…